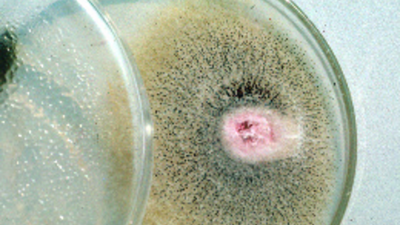
image

¿Cómo se previene el daño como consecuencia del etileno?
El etileno (C2H4), es una hormona vegetal natural incolora e inodora que aparece tanto en el interior (en las plantas) como en el exterior (en el aire). Influye en el desarrollo y el crecimiento de las plantas, incluyendo el envejecimiento de las hojas, la maduración de los frutos y la germinación de las semillas. El etileno es importante para el crecimiento de un cultivo, pero una cantidad demasiado alta puede provocar daños. Por eso es importante vigilar y controlar la cantidad de etileno en el invernadero o en el camión.

Fuentes de etileno
La mayor fuente de etileno en el invernadero, en principio es el cultivo, aunque el cultivo en sí nunca produce una cantidad dañina de etileno. Una cantidad dañina ocurre cuando también otras fuentes producen etileno. Las fuentes más comunes son:
- Calentadores que no funcionan correctamente o no están suficientemente ventilados
- Los gases de escape de los motores de combustión como la caldera o sistemas de cogeneración
- Fugas en las tuberías
- El humo del cigarrillo
- Material vegetal en descomposición
Riegos para la salud
El etileno es perjudicial para el cultivo, pero en principio no es peligroso para la salud de los humanos. Lo que es perjudicial para la salud es un alto contenido de monóxido de carbono, que a menudo resulta de una mayor concentración de etileno.
Consecuencia: un exceso de etileno
Una cantidad demasiado alta de etileno puede, como tal, causar daños. Por ejemplo, puede producirse necrosis o clorosis en la hoja, el envejecimiento acelerado de las flores se produce demasiado rápido, lo que hace que las flores se marchiten, puede producirse una deformación de las hojas y/o las flores y se puede impedir el crecimiento.
No todos los cultivos reaccionan de la misma manera a un exceso de etileno. La reacción depende de diferentes factores, incluyendo la concentración de etileno, la duración de la exposición y la temperatura del invernadero. Además, cada tipo de planta es diferente y también hay diferencias en las etapas de crecimiento.
Uso en los cultivos
Para evitar que los capullos o las flores se caigan o se deterioren, se puede aplicar Ethylene Buster. Este es un producto anti-etileno con el ingrediente activo 1-MCP. El agente se pulveriza en un espacio cerrado, por lo que el gas se adhiere a los receptores de etileno. Como resultado, las flores se mantienen frescas por más tiempo y también las plantas tienen una mayor vida útil. El Buster de Etileno puede ser usado para varias aplicaciones:
- Cultivos florales: El Ethylene Buster se utiliza para mejorar la apertura de los capullos y la vida en el florero. Además, se evita el marchitamiento prematuro o la caída de los capullos, las hojas y las flores.
- Bulbos de tulipán: El Ethylene Buster se aplica para prevenir los daños causados por el etileno, por ejemplo la adhesión (escamas mezcladas).
Además es importante realizar el tratamiento en un espacio de almacenamiento hermético. Evalúe aquí si su cultivo es sensible al etileno.
Hoja de seguridad para la aplicación del Ethylene Buster
Siempre primero compruebe si el área de tratamiento está bien cerca y si la ventilación interna está encendida. El producto consiste en una tira que contiene 10 tabletas con un activador. Realice los siguientes pasos cuando quiera aplicar Ethylene Buster:
- Abra la bolsa y deje el recipiente con la solución activa en el bloque de espuma. Retire la tapa;
- Tome el envase con dos tabletas activas azules del bloque de espuma;
- Coloque las dos tabletas en la tapa volcada. Nota: siempre use dos tabletas;
- Tomar el corrector de etileno verde del paquete del blister (ver tabla abajo)
- Ponga las pastillas verdes en la tapa volcada, junto a las dos pastillas azules;
- Saque la película de sellado del recipiente con la solución activa. Asegúrese de no derramar ninguna solución activa;
- Añada ambos colores al recipiente con la solución activa;
- Enrosque la tapa de nuevo;
- Coloque el recipiente con la solución activa en el bloque de espuma sobre una superficie estable y uniforme. Por ejemplo, en el suelo del espacio;
- Finalmente cierre la puerta en 2 minutos y manténgala cerrada al menos 4 horas para las flores y 12 horas para los bulbos de tulipán. Siempre mantenga la ventilación interna encendida para una buena circulación de aire.
Cultivo
Número de pastillas de Ethylene Buster que se necesitan
Cultivo ornamental
Usa 1 pastilla verde por 10 m3. Si el volumen a tratar es inferior de 100 m3, el número de table deberá ser redondeada:
- Si 3.47 pastillas es la dosis que corresponde, redondeamos a pastillas.
- Si 3.53 pastillas es la dosis que corresponde, redondeamos a 4 pastillas.
En caso del que el volumen a ser tratado sea mayor de 100m3, siempre redondee hacia abajo.
Bulbos de tulipán
Usa una pastilla por cada 15m3. Si el volumen a tratar es menos de 105m3, el número de pastillas debe de ser redondeado.
Nota:
- Nunca use más de 10 tabletas verdes de Ethylene Buster por recipiente. Si necesitas más divídalo entre dos o más recipientes, ambos con 2 pastillas azules.
- Siempre ventile el espacio tratado, después del proceso y manténgase fuera del lugar durante esta ventilación.
- Si usa más de un set activador, prepara todos los sets para su uso.
Siempre consulte la ficha técnica cuando se use Ethylene Buster.
Fiable, profesional y rápido
Rellene el formulario y nos pondremos en contacto con usted en 24 horas. Nuestro equipo estará encantado de atenderle.
- Más de 130 años de experiencia
- Consejos de expertos